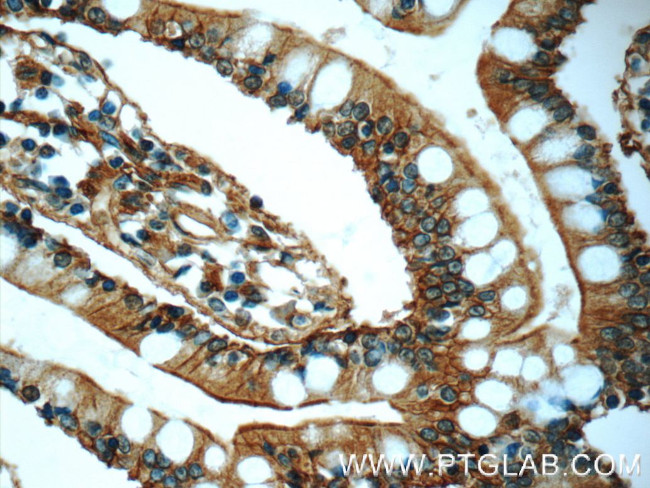
Annexin A13 Antibody in Immunohistochemistry (Paraffin) (IHC (P))

Search
Proteintech
Annexin A13 Polyclonal Antibody
{{$productOrderCtrl.translations['antibody.pdp.commerceCard.promotion.promotions']}}
{{$productOrderCtrl.translations['antibody.pdp.commerceCard.promotion.viewpromo']}}
{{$productOrderCtrl.translations['antibody.pdp.commerceCard.promotion.promocode']}}: {{promo.promoCode}} {{promo.promoTitle}} {{promo.promoDescription}}. {{$productOrderCtrl.translations['antibody.pdp.commerceCard.promotion.learnmore']}}
产品信息
25153-1-AP
种属反应
宿主/亚型
分类
类型
抗原
偶联物
形式
浓度
纯化类型
保存液
内含物
保存条件
运输条件
产品详细信息
Immunogen sequence: MGNRHAKAS SPQGFDVDRD AKKLNKACKG MGTNEAAIIE ILSGRTSDER QQIKQKYKAT YGKELEEVLK SELSGNFEKT ALALLDHPSE YAARQLQKAM KGLGTDESVL IEVLCTRTNK EIIAIKEAYQ RLFDRSLESD VKGDTSGNLK KILVSLLQAN RNEGDDVDKD LAGQDAKDLY DAGEGRWGTD ELAFNEVLAK RSYKQLRATF QAYQILIGKD IEEAIEEETS GDLQKAYLTL VRCAQDCEDY FAERLYKSMK GAGTDEETLI RIIVTRAEVD LQGIKAKFQE KYQKSLSDMV RSDTSGDFRK LLVALLH (1-316 aa encoded by BC125158)
靶标信息
This gene encodes a member of the annexin family. Members of this calcium-dependent phospholipid-binding protein family play a role in the regulation of cellular growth and in signal transduction pathways. The specific function of this gene has not yet been determined; however, it is associated with the plasma membrane of undifferentiated, proliferating endothelial cells and differentiated villus enterocytes. Alternatively spliced transcript variants encoding different isoforms have been identified.
仅用于科研。不用于诊断过程。未经明确授权不得转售。
篇参考文献 (0)
生物信息学
蛋白别名: Annexin A13; Annexin XIII; annexin, intestine-specific; Annexin-13; Intestine-specific annexin; ISA
基因别名: 1810034H17Rik; ANX13; ANXA13; AV055219; ISA
UniProt ID: (Human) P27216, (Mouse) Q99JG3
Entrez Gene ID: (Human) 312, (Mouse) 69787